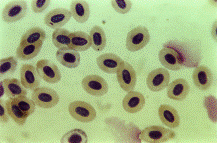

Эколого-генетический мониторинг водоемов вблизи биостанции Ажендарово
Министерство
образования и науки РФ
Государственное
образовательное учреждение высшего
профессионального образования
Кемеровский
государственный университет (КемГУ)
Биологический
факультет
Кафедра
Генетики
КУРСОВАЯ
РАБОТА
Эколого-генетический
мониторинг водоемов вблизи биостанции Ажендарово
Кемерово
2011
ОГЛАВЛЕНИЕ
ВВЕДЕНИЕ
ГЛАВА
1. ОБЗОР ЛИТЕРАТУРЫ
1.1
Биология вида, ареал. Описание Carassius
gibelio и близкого вида C.carassius.
Таксономия
.2
Физико-географическая характеристика района исследования
1.3
Микроядра
.4
История Микроядерного теста
.5
Сферы использования микроядерного теста
ГЛАВА
2. МАТЕРИАЛЫ И МЕТОДЫ ИССЛЕДОВАНИЯ
ГЛАВА
3. РЕЗУЛЬТАТЫ И ОБСУЖДЕНИЯ
ВЫВОДЫ
СПИСОК
ЛИТЕРАТУРЫ
ВВЕДЕНИЕ
В настоящее время стало очевидным, что биосфера
все более и более загрязняется самыми разнообразными соединениями, с которыми в
своем историческом развитии человек не сталкивался. В этой связи в
первоочередную задачу исследователей входит поиск и разработка методов, с
помощью которых возможно достаточно четко и быстро определить кластогенность и
канцерогенность как вновь синтезируемых соединений, так и веществ, широко
применяемых в быту, промышленности, сельском хозяйстве и медицине, одним из
таких методов является микроядерное тестирование (Новицкий, Климова, 1989).
Микроядерное тестирование - один из эффективных
методов, позволяющих определить суммарное воздействие токсинов на структуру
хромосом и выявить генетические изменения у конкретной особи. Хроническое
воздействие неблагоприятных факторов на организм приводит к нарушению
цитогенетической стабильности и накоплению хромосомных аномалий в клетках
организма (Ильинских и др., 2001).
Актуальность выполняемой работы обусловлена
необходимостью проведения научной комплексной оценки современного состояния
экологических параметров водной среды.
Целью данной работы является оценка фонового
уровня мутаций в популяции Серебряного карася (Carassius gibelio) в
окрестностях биостанции Ажендарово.
Задачи:
. Изучить спонтанный уровень цитогенетических
нарушений методом микроядерного анализа в эритроцитах серебряного карася,
обитающего в водоемах биостанции Ажендарово.
ГЛАВА 1. ОБЗОР ЛИТЕРАТУРЫ
.1 Биология вида,
ареал. Описание Carassius
gibelio и близкого вида C.carassius.
Таксономия
Из всех рыб нашей ихтиофауны, караси бесспорно
являются весьма неприхотливым видом, наряду с случайным аклиматизантом,
ротаном-головешкой (Percottus
gleeni). Можно сказать,
что иногда караси появляются в совершенно обособленных водоемах, где любая
другая рыба отсутствует, конечно же, это легко объясняется, тем, что икра
заносится водоплавающими птицами, после чего, скорее всего озеро будет
перенаселено карасями, причем серебряный более неприхотлив и распространен,
нежели его собрат карась золотой. И так как за объект исследования, за модель,
типичного представителя был взят именно серебряный карась, то говорить мы
больше будем о нем.
Ареал C.gibelio
весьма обширен и охватывает внутренние водоемы Евразии и Северной Америки
умеренного климата. В Западной Сибири он обитает в бассейне реки Оби и озерах,
в таких реках как: Обь, Иртыш, Тобол, Томь, Чулым и т. д., наряду с золотым
карасем, хотя второй чаще обитает в озерах, стоит также заметить что ареал и
численность C.carassius
в последнее время резко сокращается. «В бассейне Оби известен от верховьев до
дельты». И лишь нет его вероятно в быстрых горных речках, т. к. это очень
несвойственное место обитания для карася. По словам П.А. Попова (2005) кроме
карася - аборигена широко распространен серебряный карась из бассейна реки
Амур, и в настоящее время хорошо адаптировавшийся к местным условиям обитания,
и в ряде водоемов полностью вытеснил аборигенный вид. Ареал карася охватывает
озера и речные системы Байкала и Забайкалья. В реках Восточной Сибири, вплоть
до р. Колымы; обитает серебряный карась и в Якутии. Но, по мнению ряда
ихтиологов, он представлен не типичной а «якутской» морфологической формой
(Попов, 2005). Б.В. Силин на основании проведенного им в 1983 г сравнительного
морфо - экологического анализа карасей из Якутии, и типичного карася из
водоемов Сибири и Европейской части России, пришел к выводу, что «якутского»
карася следует рассматривать в качестве подвида серебряного карася C.auratus
gibelio (Bloch),
размножающегося с участием самцов своего вида (Попов, 2005). Что в свою очередь
ошибочно. Озера полуострова Камчатки и о. Сахалин также не лишены серебряного
карася.
Число жаберных тычинок в количестве от 31-51
является характерным признаком C.gibelio,
но чаще всего их 44-47 , глоточные зубы однорядные: 4 - 4, позвонков 29 - 33.
Кариотип диплоидной формы 2n
= 140, NF = 148,
триплоидной 3n = 162, NF
= 348. Продолжительность жизни 15-17 лет, но зачастую возраст не превышает 5+,
6+; при благоприятных условиях достигают длины 45 см и массы 2 кг.
Половозрелыми становятся в возрасте 2+ в лесостепной, южной части Западной
Сибири, и в 5+, 6+ в бассейне реки Надым, предположительно можно провести связь
с широтной зональностью, скорее всего сроки полового созревания возрастают с
юга на север, чем севернее живет популяция, тем позже у них наступает
половозрелость. Икра серебряного не слишком крупная, плодовитость индивидуальна
и колеблется по П.А. Попову у разных популяций из самых различных мест Сибири,
от 4-254 тыс. икринок. Вымет икры проходит в один прием, t
воды и сроки нереста также весьма разнообразны. Питается карась преимущественно
зоопланктоном и зообентосом, а также водорослями и детритом, в целом к пищи не
прихотлив. Именно не прихотливость карася способствует широкому расселению и
высокой численности этого вида во многих водоемах нашей области, как и
большинстве водоемов умеренного климата северного полушария.
Касательно таксономии рода Carassius
Jarocky, 1822 вида можно
сказать следующее: типовой вид Cyprinus
carassius (Linnaeus
1758), название же Carassius
снабжено пространным диагнозом рода к которому отнесено три вида. Это китайский
карась (Carassius
auratus), который как не
странно по латыни звучит как ауратус он же золотая рыбка, который обитает
только в Японии и Китае и на территории России не встречается, был
интродуцирован в годы СССР, но натурализации как видимо не произошло; золотой
карась он же обыкновенный (Carassius
carassius); и серебряный
карась (Carassius
gibelio). Ранее считали
название carassius
из не пригодным так как публикации никто не видел.
Валидное научное название серебряного карася
можно считать предметом спора и обращения в Международную комиссию по
зоологической номенклатуре, так как синтипы Cyprinus
gibelio Bloch,
1782 являются экземплярами обыкновенного (золотого) карася. Традиционно его
рассматривали как подвид китайского карася, одичавшую золотую рыбку или ее
гибрид. Дискуссии по этому поводу можно найти в ряде публикаций
По мнению исследователей генетиков, триплоидные C.gibelio
являются результатом гибридизации C.auratus
с каким то неизвестным, вероятно вымершим видом или же несколькими. Также
наряду со всем выше описанным следует сказать, что наряду с двуполыми и
однополыми карасями существуют и гемафродитические особи и даже целые
популяции.
В целом, подходя к вопросу о серебряном карасе
мы не можем сказать что же перед нами, или в рамках теории сетчатого
видообразования считать диплоидные и полиплоидные формы видами двойниками, или
же назвать все это «диплоидно-триплоидным» комплексом. Какова же
морфометрическая изменчивость и диагностические признаки и существует ли
определенная закономерность для разных или даже однотипных водоемов мы тоже не
можем сказать (Попов, 2005).
.2 Физико-географическая характеристика района
исследования
Исследование происходило в озерах - старицах
поймы реки Томи среднего течения в районе биостанции «Ажендарово» КемГУ,
Крапивинского района нашей области, в местах перехода лесостепной зоны в
черневую тайгу, где озера старицы по левому берегу, образуют густую сеть,
состоящую примерно из 50 водоемов разнообразных по своим условиям обитания,
формой дна, зеркалом поверхности, растительностью, составом ихтиофауны, и
характером соединения между собой и с р. Томь. Все это дает возможность
исследования жизнедеятельности и морфологической изменчивости серебряного
карася в зависимости от изменения внешних факторов окружающей среды, и
взаимопроникновение смешивание популяций из разных озер и особей из реки Томь.
Озера поймы Томи нельзя упоминать, не сказав и о
самой реке. Правый берег реки обрывистый, и рельеф плавно перерастает в невысокие
хребты отрои Кузнецкого Алатау. Левобережную пойму и всю сеть озер окружает
Ажендаровский хребет и другие возвышенности с юго-запада, где и проявляются
экологические тональности перехода от лесостепи к смешанному лесу и затем к
черневой тайге. Сами озера очень разные и имеют разную форму, самые удаленные
соединяются с Томью через сеть протоков или другие озера, и поэтому их
ихтиофауна не смешивается с фауной Томи также бывает, что озеро изолировано
полностью от других водоемов и только водоплавающие птицы могут случайно
занести икру других рыб.
Климат, охватываемого картой, участка реки Томь
- континентальный, для него характерны тёплое лето и холодная зима.
Температура воздуха весной повышается
постепенно. Переход среднесуточных температур через 0 градусов происходит
обычно в середине апреля. Снежный покров сходит в последней декаде апреля или в
первой декаде мая. Последние заморозки наблюдаются в конце мая - начале июня.
Иногда в мае выпадает снег. Самым тёплым летними месяцами является июль,
средняя месячная температура 18-20 градусов. Максимальная температура за
многолетний период 37-39 градуса (Кемеровская
область…, 2004).
Осень продолжительнее и, как правило, теплее
весны. Первые заморозки наблюдаются обычно в середине сентября, но в отдельные
годы отличаются уже в конце августа. Иногда осень бывает сухой и тёплой.
Переход среднесуточной температуры воздуха через ноль градусов происходит
обычно в первой половине октября. Самым холодным зимнем месяцем является
январь, среднемесячная температура, которая минус 19-20 градусов. Минимальная
температура за многолетний период минус 45-49 градусов. В отдельные годы
возможно повышение температуры, до плюс 40 градусов.
Средняя высота снежного покрова 4-60см, но
местами может достигать 100см.
Ветры. Преобладающими ветрами в течение года
явлются ветры южного направления с повторяемостью 25% и юго-западного с
повторяемостью 24%. В течение всего года преобладают ветер со скоростью 3-4
метра в секунду. Штормовые ветры со скоростью более 15 метров в секунду
наблюдаются преимущественно в мае и сентябре-октябре.
Туманы наиболее часты осенью, главным образом
ночью и утром. Продолжительность туманов различная, но в разных случаях они
держатся более 7 часов.
Осадки. Среднегодовое количество осадков
составляет 480-600мл. наибольшее число дней с осадками приходится на период с
мая по октябрь. Летом осадки выпадают в виде кратковременных явлений, иногда
сопровождаются грозами. Часто идут продолжительные обложные дожди.
Колебания уровня. Основное питание реки Томи
получает от таяния снегов и от дождевых вод. Весеннее половодье продолжается
1,5-2,5 месяца. Высота подъема уровня воды составляет 6-10метров над проектным
уровнем. В течение летних месяцев могут быть дождевые паводки с амплитудой
колебания уровня от 1 до 3 метров. Осенний паводок приходиться на
сентябрь-октябрь и по величине может быть различным.
Межень наступает в июле-августе. Начало
меженного периода определяется наступлением уровня воды.
Течение. Средняя скорость течения реки Томи
весной составляет 7-10 километров в час, межень 3-5 километров в час. При
высоких уровнях воды, некоторых участках при низких уровнях в изгибах и
узкостях наблюдаются прижимные течения, а в местах разветвления реки на протоки
затяжение течения на многих участках действует свальные течения (Кемеровская
область…, 2004).
Ледовый режим. Вскрытие реки и распространение
волны весеннего половодья происходит сверху вниз. Весенний ледоход на реке Томи
сопровождается кратковременными подъемами уровня воды и продолжается в среднем
от 3 до 10 суток. Продолжительность осеннего ледохода составляет 9-29 суток.
Местами образуются полыньи. Толщина льда достигает 70-80 сантиметров. Вскрытие
озер же происходит в разное время в зависимости от рельефа дна и многих других
причин, но естественно, что стоячие воды освобождаются от ледяного покрова
значительно позже, нежели проточные.
На реке Томи два максимальных стока: во время
весеннего половодья и в период выпадения осенних дождей. Этим повышениям
расхода воды соответствуют два понижения минерализации воды. В период весеннего
половодья вода мало минерализована, сумма ионов составляет 32-78 мг/л. В
летне-осеннюю межень, минерализация воды увеличивается до 100-184 мг\л, в
зимнюю межень - до 123-138мг\л.
Во все фазы водного режима вода имеет хорошо и
резко выраженный гидрокарбонатный характер с преобладанием иона Са в составе
катионов.
Насыщение кислородом в период открытого русла
колеблется в пределах 64-99% (6-13 мг\л), в зимнюю межень снижается до 20-39%
(4-7,5 мг\л). Величина рН в течение года колеблется в пределах 6,8-7,8.
Вследствие многолетнего загрязнения реки
гидрохимический режим Томи резко изменился. В реке в значительном количестве
обнаруживаются такие вещества, как нефтепродукты, фенол, метанол, тетраэтил,
формальдегид и соли тяжелых металлов.
В августе - сентябре увеличивается содержание в
воде биогенных элементов, что связано с повышением температуры воды и,
следовательно, с усилением биологических процессов, происходящих в ней (Кемеровская
область…, 2004).
.3 Микроядра
Микроядра (МЯ) - это небольшие ДНК-содержащие
тельца, существующие в клетке отдельно от основного ядра (ядер) или связанные с
ними хроматиновым мостом. Известно, что микроядра представляют собой небольшие
образования, состоящие из фрагментов хромосом. На стадии телофазы эти фрагменты
могут включаться в ядра дочерних клеток или образовывать одиночные или
множественные микроядра в цитоплазме. Крупные микроядра формируются при
патологических митозах, что обусловлено отставанием отдельных хромосом в
метафазе и в анафазе, в то время как мелкие микроядра встречаются
преимущественно при структурных аберрациях хромосом. Кроме того, микроядра
могут появляться в следствие апоптоза (Воронов, 1929). Их возникновение
связывают, как правило, с такими типами повреждения генома как ацентрические
фрагменты хромосом или целые хромосомы, отставшие в ана-телофазе митоза от
веретена деления и не вошедшие в дочерние ядра. Строго такой механизм
образования МЯ был доказан in vivo для проэритробластов мыши и in vitro для
лимфоцитов человека. В то же время в исследованиях на разных клеточных линиях
было показано, что образование микроядра - это не всегда только
постмитотическое событие (Куминова, 1950). Например, МЯ могут образовываться в
фазе синтеза ДНК из ядерных почек, а также, видимо, во всех тех случаях, когда
клетка избавляется от избытка ДНК (избыточная амплификация, реверсия культур
клеток опухоли путем экскреции онкогенов). Таким образом, микроядро - это
свидетельство количественных изменений ДНК в живой клетке. Микроядра впервые
обнаружил Howell в 1890 г в эритроцитах периферической крови анемизированных
кошек образования, которые были слишком велики для гранул и по размерам
соответствовали большому ядрышку. Эти образования как правило, располагались на
периферии клеток, окрашивались метиленовым зелёным и по мнению Howell,
представляли собой остатки ядра, которые не были вытолкнуты из клетки
вследствие ускоренного созревания ядерных форм эритроцитов в условиях
стимуляции процессов регенерации эритропоэза (Воробьев, Лорие, 1985).
.4 История микроядерного теста
Разработку микроядерного теста обычно связывают
с именем Schmid, хотя он был предложен почти одновременно в 1970-1973 гг.
несколькими группами исследователей. Метод быстро получил распространение, и по
данным Hayashi, уже к 1990 г. имелось не менее 800 работ по микроядерному
тесту. К 1998-2000 гг. количество исследований, выполненных с использованием
микроядерного теста, уже исчисляется порядка 5-7 тыс. и продолжает
увеличиваться чрезвычайно быстрыми темпами. Появилось несколько обзоров,
посвященных результатам микроядерного анализа. В США в рамках токсикологической
программы агентства по охране окружающей среды создана рабочая группа из
наиболее видных специалистов по микроядерному анализу, которая подготовила
соответствующие методические рекомендации. В настоящее время микроядерный тест
включен как обязательный при токсикологических исследованиях в странах
Европейского экономического сообщества и Японии. Широко используют микроядерный
тест и в других странах. Особенно это наглядно видно при анализе работ, представленных
на 18-й и 19-й конференциях Европейского общества по изучению мутагенов внешней
среды, а также на 5-й международной конференции по мутагенам (Ильинских, 1989).
Наблюдение за линейными животными
свидетельствует, что различные линии обладают разной мутагенной
чувствительностью. Исходя из этого следует предполагать, что и в популяциях
человека имеются индивидуумы с различной мутагенной чувствительностью. Исходя
из этого следует предполагать, что и в популяциях человека имеются индивидуумы
с различной резистентностью к мутагенным факторам. Особое внимание в этой связи
следует обращать на те из них, у кого выражена нестабильность генома (Журков и
др., 1986). Однако до последнего времени не существовало метода, позволяющего
оценить с генетических позиций большие контингенты населения, выделить лиц,
предрасположенных к нестабильности генома с целью выделения особых групп
генетического риска. С появлением микроядерного теста стало возможным провести
такую работу, поскольку, по сравнению с уже имеющимся на вооружении генетиков
методами, микроядерный тест наименее трудоёмок и наиболее производителен, хотя
и не лишён некоторых недостатков (Гончарова, 1984).
Тем не менее, до сих пор среди ученых
использующих в своих исследованиях микроядерный тест нет единого мнения по
разным сторонам применимости микроядерного теста, поскольку результаты
исследований проведенных в разных лабораториях мира зачастую не совпадают. В
связи с этим в 1998 году был создан международный комитет HUMN-project, в
задачи которого вошло стандартизовать методические подходы к использованию
микроядерного теста при изучении мутагенов окружающей среды. В настоящем
исследовании представлены данные по методическим подходам в использовании
микроядерного теста и применимость этих подходов в скрининге и мониторинге
генотоксического загрязнения некоторых территорий Сибири (Ильинских, 1989).
.5 Сферы использования микроядерного теста
Микроядерный тест является косвенным методом
оценки наличия хромосомных повреждений. Например, определение микроядер в
лейкоцитах зарекомендовало себя в качестве специфичного и высокоинформативного
способа идентификации разрывов хромосом. На основании данных, полученных при
исследованиях in vivo и in vitro, было установлено, что показатель,
характеризующий появление микроядер более информативен, чем регистрация
хромосомных аберраций, а наличие микроядер в клетках следует считать маркером
генетической нестабильности (Межжерин, Кокодий, 2008).
Повреждение хромосом, и формирование микроядер
часто наблюдается при новообразованиях, что дает возможность применения
микроядерного теста для прогнозирования онкологических заболеваний. Показаны
различия в частоте встречаемости микроядер у онкологических больных и лиц, не
имеющих данной патологии. Выявление микроядер в клетках широко используются в
клинической практике для диагностики заболеваний и прогнозирования их течения,
а так же при проведении исследований, связанных с уточнением особенностей
развития патологического процесса (Выскубенко, 1989).
Клетки, содержащие микроядра, часто образуются в
результате влияния физических факторов и при воздействии токсических веществ.
Многие учёные отмечают наличие генетически предопределенного характера
устойчивости по отношению к факторам химической и физической природы, что
обусловливает разное соотношение не измененных клеток и содержащих микроядра,
при этом был установлен дозозависимый эффект воздействия указанных факторов на
образование микроядер (Хева и др., 1996).
Радиоактивное излучение вызывает увеличение
частоты встречаемости клеток с микроядрами, поскольку рентгеновское и
гамма-излучение индуцируют повреждение клеток (Титенко, Евсиков, 1987).
Существуют данные, указывающие на возможность появления микроядер в ответ на
проведение лучевой терапии, при этом частота встречаемости этих структур
зависит от выбранного метода лечения. В то же время при проведении клинического
исследования трудно исключить влияние сопутствующих факторов, являющихся
компонентами терапевтического воздействия, или элементами окружающей среды,
вызывающими формирования микроядер. Поскольку радиоактивное излучение
индуцирует появление клеток, содержащих микроядра, то микроядерный тест может
быть с успехом использован для контроля эффективности радиопротекторов
(Джикидзе и др., 1990).
Использование микроядерного теста весьма
информативно для контроля влияния факторов окружающей среды на организм
человека. Исследователями был установлен факт увеличения числа клеток с
микроядрами в мокроте у лиц, проживающих в крупных городах. Не случайный
характер таких результатов связан, в том числе, с непосредственным воздействием
загрязненного воздуха на клетки респираторного тракта. Регистрация микроядер
представляет собой простой и в то же время эффективный метод оценки воздействия
газообразных веществ, попадающих в организм ингаляционным путем. Соотношение
жизнеспособных клеток и клеток, содержащих микроядра, является важным
показателем при цитологических исследованиях.
Достаточно часто объектом микроядерного анализа
выступают такие клетки, как альвеолярные макрофаги, лимфоциты периферической
крови и эпителиальные клетки (Хэм, Кормак, 1983).
Большие размеры альвеолярных макрофагов
позволяют точно и безошибочно проводить идентификацию содержащихся в них
микроядер. Показана обоснованность и эффективность данного метода, который,
вероятно, имеет и некоторые ограничения, связанные с трудностью определения
размеров микроядер при плохом распластывании цитоплазмы. Логично предположить,
что для повышения информативности цитологических исследований целесообразно
использовать предварительную инкубацию, позволяющую клеткам хорошо
распластаться по подложке, и тем самым облегчить задачу идентификации
микроядер. В то же время нужно учитывать и условия инкубации клеток, поскольку
их влияние на активность образования микроядер не вызывает сомнения (Фельдт,
Журков, 1994),
Микроядерный тест достаточно информативен в
плане определения влияния мутагенов на клетки, непосредственно контактирующие с
факторами окружающей среды, и его следует использовать для определения степени
риска развития заболеваний у контингента, работающего во вредных условиях. При
этом изменение количества клеток с микроядрами учитывают при исследовании
эффективности воздействия протекторов, защищающих организм от влияния
токсических веществ.
Исходя, из вышеизложенного следует, что
воздействие биологических, химических и физических факторов закономерно
вызывает образование микроядер, а идентификация этих структур помогает выявить
нестабильность функционирования клеток. При этом существуют генетически
детерминированные особенности, определяющие активность формирования микроядер
(Гаврилов и др., 1985).
Регистрация структурно-функциональных изменений,
при которых в клетках выявляется наличие микроядер, представляет собой
высокоинформативный и вместе с тем простой в техническом отношении метод оценки
влияния на организм различного рода факторов окружающей среды, что позволяет
считать его одним из элементов мониторинга влияния не благоприятных
составляющих, которые контролируют развитие целого ряда заболеваний.
Микроядерный тест находит применение в
клинической практике для диагностики заболеваний и прогнозирования их течения,
а доступность лимфоцитов периферической крови многократно повышает практическую
значимость данного метода. Кроме того, многие экспериментальные исследования,
особенно связанные с тестированием химических соединений, не обходится без
микроядерного анализа (Гольдберг, 1938).
Таким образом, ряд патологических процессов,
лежащих, в основе достаточно большого количества заболеваний сопровождается
формированием микроядер (Козаченко, Соболева, 1984).
мутация карась цитогенетический
микроядерный
ГЛАВА 2. Материалы и
методы ИССЛЕДОВАНИЯ
Наиболее удобным тест-объектом генетической
индикации водной среды являются рыбы как типичные гидробионты, присутствующие
повсеместно в наших водоемах. Тест-системой для проведения
эколого-генетического мониторинга является микроядерный тест, предусматривающий
учет количества микроядер (мутаций) в клетках рыб. Данный тест объективно
характеризует частоту хромосомных нарушений в ходе митоза, а именно: разрывы
хромосом, отставание отдельных хромосом в ходе деления клеток. Подходящими
клетками для анализа являются эритроциты крови, которые у рыб имеют достаточно
крупные размеры и обладают ядром. Таким образом, рыбы могут играть роль
модельных объектов при определении потенциально опасных для человека
генотоксичныих веществ в воде (Журков, Фельдт, 1989).
В ходе практики в водоёмах находящихся вблизи
биостанции Ажендарово был проведён отлов экземпляров серебряного карася.
Непосредственно после отлова у каждого экземпляра были отобраны образцы цельной
крови из сосудов хвостового стебля. Каплю крови немедленно помещали на чистое,
обезжиренное предметное стекло с последующим приготовлением мазка. После
высыхания на воздухе зашифрованный препарат фиксировали в этаноле в течение 30
мин. Известно, что для оценки качества среды могут быть использованы разные
подходы (Гольдберг, 1937). Помимо прямого определения содержания и концентраций
различных химических и радиационных загрязнителей среды, особое значение
отводится системе биологической индикации, главным компонентом которой является
эколого-генетический мониторинг, позволяющий в наиболее полной мере оценивать
качество экологических параметров конкретной среды. Микроядра в микроскопе
видны как небольшие округлые, без острых углов, но с чётким контуром, густо
окрашенные тельца, реже - замкнутые или разорванные кольца. «Истинное»
микроядро должно быть видно в эритроците, обычно ближе к периферии и находиться
в фокусе, когда чётко виден контур эритроцита. (Кассирский, Алексеев, 1970).
При смещении объектива микроскопа «истинные» микроядра не должны сдвигаться
относительно контура эритроцита. Если в поле зрения между эритроцитами много
осажденных гранул красителя, то такой препарат нельзя использовать для
микроядерного анализа. Окрашивание препаратов проводили в течение 15 мин. 5%
раствором красителя Гимза (Merk), приготовленного на фосфатном буфере pH - 6,8.
Окрашенные препараты промывали дистиллированной водой и сушили на воздухе.
Цитогенетический анализ проводили под световым микроскопом Nikon eclipse - E200
с использованием увеличения х 1000. От каждого экземпляра анализировали по 1000
полихроматофильных эритроцитов. Оценку достоверности различий по изучаемым
цитогенетическим параметрам проводили непараметрическим методом с
использованием критерия Манна-Уитни
Рисунок 2. Микрофотография препарата цельной
крови Серебряного карася (х 400)

Рисунок 3. Микроядро в эритроците Серебряного
карася (х 1000)
ГЛАВА 3. Результаты и
обсуждение
В табл. представлены результаты
цитогенетического анализа микроядер в эритроцитах сибирского хариуса,
полученные ко времени подготовки отчета для двух точек контрольного отлова:
р.Томь (Затон) и оз. Ажендарово. Как следует из данных табл.1, доля клеток,
содержащих в своем составе мутации хромосом (микроядра) в выборке серебряного
карася обитающего в р.Томь составила в среднем 0.57±0.30‰. Это значение
оказалось достоверно (р = 0,007)
ниже
аналогичного показателя (1.33±0.71‰), выявленного в выборке карася обитающего в
оз. Ажендарово (группа сравнения).
Таблица
Фоновый уровень микроядер в эритроцитах
Серебряного карася, обитающего на территории биостанции «Ажендарово»
|
Исследуемая
выборка
|
Число
экземпляров
|
Число
клеток
|
Доля
клеток с микроядрами, ‰, M
± m
|
Доля
клеток с мостом, ‰, M
± m
|
|
р.
Томь (Затон)
|
6
|
6000
|
0.57±0.30
|
0.14±0.14
|
|
оз.
Ажендарово
|
7
|
7000
|
1.33±0.71
|
0.17±0.17
|
Доля клеток с мостом, которая оценивалась в
сравниваемых выборках в качестве дополнительного цитогенетического показателя,
также оказалась ниже в популяции серебряного карася обитающего в р. Томь
(0.14±0.14 ‰ и 0.17 ± 0.17‰ соответственно), однако эти различия оказались
недостоверны (р>0,05).
Выводы
1. Микроядерный тест в эритроцитах серебряного
карася оказывается достаточно чувствительным для проведения биологического
мониторинга за генотоксическими параметрами водной среды.
2. Уровень микроядер в эритроцитах серебряного
карася, обитающего в озере Ажендарово, достоверно превышает аналогичный
показатель для выборки из Ажендаровского затона р. Томь.
СПИСОК ЛИТЕРАТУРЫ
1. Воробьев,
А.И. Руководство по гематологии / А.И. Воробьев, Ю.И. Лорие. - М.: Медицина,
1985. - 367 с.
2. Воронов,
А.П. О морфологических изменениях крови в кроветворных органах под влиянием
бензола и его производных / А.П. Воронов // Тр. X съезда терапевтов СССР. - М.,
1929. - С.12-20.
. Выскубенко,
И.Ф. Применение микроядерного теста для выявления органоспецифичности
потенциальных канцерогенов / И.Ф. Выскубенко // Всесоюз. симпоз. «Объем и
методы генотоксической оценки и побочных эффектов биологически активных
веществ». - Л., 1989. - 25 с.
. Гаврилов,
O.K. Клетки костного мозга и периферической крови / О.К. Гаврилов, Г.И.
Козинец, И.Б. Черняк. - М.: Медицина, 1985. - 281 с.
. Гольдберг,
Д.И. Метод обогащения препаратов базофильно-зернистыми эритроцитами / Д.И.
Гольдберг. - М., 1937. - С. 102-104.
. Гольдберг,
Д.И. О так называемой зернистой дегенерации гемоглобина, обнаруживаемой при
суправитальной окраске / Д.И. Гольдберг. - М., 1938. - С. 125-127.
. Гончарова,
Р.И. Мутагенная активность диметилтерефталата при использовании микроядерного
теста на мышах / Р.И. Гончаров // XIV ежегодная конференция Европейского
общества по мутагенам внешней среды. - М., 1984. - 199 с.
. Джикидзе,
Э.К. Морфологические и цитогенетические изменения в костном мозге обезьян в
отдаленные сроки после хронического облучения в малых дозах / Э.К. Джикидзе,
Л.П. Косиченко, М.И. Куксова // Радиобиология. - Томск, 1990. - С. 281-285.
. Журков,
B.C. Анализ частоты нормохромных эритроцитов с микроядрами в периферической
крови мышей как метод выявления мутагенов / В.С. Журков, П. Реснер, А.
Басторнова, Е.Г. Фельдт // Бюл. эксперим. биол. и мед. - 1986. - № 8. - С.
222-224.
. Журков,
B.C. Метод учета полихроматофильных эритроцитов с микроядрами в костном мозге
млекопитающих / В.С. Журков, Е.Г. Фельдт // Статистическая обработка данных
тестирования на мутагенность: Методические указания. - Вильнюс, 1989. - С.
29-31.
. Ильинских,
Н.Н. Биологические факторы мутагенеза у человека / Н.Н. Ильинских // Генетика
человека и патология. - Томск, 1989. - 68 с.
. Ильинских,
Н.Н. Физиологические факторы мутагенеза в связи с изменением иммунореактивности
организма / Н.Н. Ильинских // III школа-семинар по генетике и селекции
животных. II научные чтения памяти академика Д.К. Беляева. - Новосибирск, 1989.
- 47 с.
. Ильинских,
Н.Н. Использование микроядерного теста в скрининге имониторинге мутагенов / Н.Н.
Ильинских, И.Н. Ильинских, В.Н. Некрасов // Цитология и генетика. - 2001. - Т.
22, № 1. - С. 67-72.
. Кассирский,
И.А. Клиническая гематология / И.А. Кассирский, Г.А. Алексеев. - М.: Медицина,
1970. - 999с.
. Кемеровская
область. // Большая Энциклопедия Кирилла и Мефодия. Электронная версия. - М.,
2004
. Козаченко,
В.И. Возможности метода учета микроядер в эритроцитах печени эмбрионов мьши /
В.И. Козаченко, Л.С. Собалева // Взаимодействие между преобразованиями
окружающей среды и адаптивной, демографической и генетической структурой
народонаселения. - М., 1984. - 109 с.
17. Куминова,
А. В. Растительность Кемеровской области / А. В. Куминова. - Новосибирск, 1950.
- 253 с.
18. Новицкий,
В.В. Отдаленные последствия повреждающего действия цитостатических препаратов
на кроветворение и лимфоидную ткань / В.В. Новицкий, М.Ю. Климова // Бюл. Том.
науч. центра АМН СССР. - Томск, 1989. - С. 54-64.
19. Межжерин,
С.В. Поликлоновая структура европейских серебряных карасей Carassius auratus s.
lato в водоемах Украины / С.В. Межжерин, С.В. Кокодий // Доповіді НАН України.
- 2008. - C. 162-169.
. Попов,
П.А. Оценка экологического состояния водоемов методами ихтиоиндикации / П.А
Попов. - Новосибирск, 2002. - 270 с.
. Титенко,
Н.В. Микроядра и цитогенетические нарушения в эмбрионах мышей до имплантации /
Н.В. Титенко, В.И. Евсиков // Цитология и генетика. - 1987. - Т. 11, № 1. - С.
17-21.
. Фельдт,
Е.Г. Изучение мутагенного действия бензола и толуола в соматических и половых
клетках млекопитающих / Е.Г. Фельдт, В.С. Журков // XIV ежегод. конф.
Европейского общества по мутагенам внешней среды. - М., 1994. - 164 с.
. Хева,
С.Н. К механизму образования микроядер в ФГА-стимулированных лимфоцитах
периферической крови человека / С.Н. Хева, Л.В. Щедрина, Р.П. Степанов //
Цитология. - 1996. Т. 28. - С. 227-231.
. Худолей,
В.В. Ретроспективная оценка генотоксичности канцерогенных для человека
химических соединений / В.В. Худолей, Г.А. Белицкий // Всесоюзн. симпоз. «Объем
и методы генотоксической оценки и побочных эффектов биологически активных
веществ». - JI., 1998. - С. 101-102.
. Хэм,
А. Гистология / А. Хэм, Д. Кормак. - М.: Мир, 1983. - 254 с.